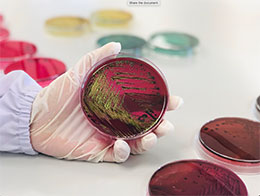
Biotherapeutics

Disease Prevention and Treatment
Diet
 The PMD diet-microbiome working group supports clinical studies of the efficacy of dietary interventions to shape the gut microbiome and reduce inflammation associated chronic diseases such as inflammatory bowel diseases or IBD. Historically, IBD is known to affect more people of Caucasian origin than other ethnic groups; however, there is emerging evidence that the prevalence of IBD in Hispanics may be increasing, along with the general U.S. population. Thus, research from the PMD focuses on clinical translational projects to study the relation of diet and the gut microbiota in IBD severity in both Caucasian and Hispanic patients. We expect that results from our studies will guide the development of culturally tailored behavioral intervention, with targeted dietary recommendations aimed at modifying the gut microbiota to improve IBD symptomatology.
The PMD diet-microbiome working group supports clinical studies of the efficacy of dietary interventions to shape the gut microbiome and reduce inflammation associated chronic diseases such as inflammatory bowel diseases or IBD. Historically, IBD is known to affect more people of Caucasian origin than other ethnic groups; however, there is emerging evidence that the prevalence of IBD in Hispanics may be increasing, along with the general U.S. population. Thus, research from the PMD focuses on clinical translational projects to study the relation of diet and the gut microbiota in IBD severity in both Caucasian and Hispanic patients. We expect that results from our studies will guide the development of culturally tailored behavioral intervention, with targeted dietary recommendations aimed at modifying the gut microbiota to improve IBD symptomatology.
Highlighted Publications:
- A dietary intervention to improve the microbiome composition of pregnant women with Crohn's disease and their offspring: The MELODY (Modulating Early Life Microbiome through Dietary Intervention in Pregnancy) trial design
- Associations between diet, the gut microbiome, and short-chain fatty acid production among older caribbean latino adults
Live biotherapeutics:
PMD members are leveraging our computational, experimental, and synthetic biology infrastructures to discover new live bacteriotherapeutics for curing a range of inflammatory and infectious diseases. We currently have four programs devoted to this initiative: Program 1: Discover novel probiotic combinations to achieve multi-drug resistant Enterobacteriaceae decolonization in the GI tract; Program 2: Optimize and test our new class of genetically engineered probiotics to eradicate multi-drug resistant Enterobacteriaceaespecies; Program 3: Develop another novel probiotic to sense Clostridium difficile expansion in the infected gut and to eradicate it through the production of C. difficile inhibitory compounds; and Program 4: Develop probiotic consortia to minimize the emergence of stress-induced physiological, neurological and behavioral negative outcomes including anxiety and PTSD.
PMD members are leveraging our computational, experimental, and synthetic biology infrastructures to discover new live bacteriotherapeutics for curing a range of inflammatory and infectious diseases. We currently have four programs devoted to this initiative: Program 1: Discover novel probiotic combinations to achieve multi-drug resistant Enterobacteriaceae decolonization in the GI tract; Program 2: Optimize and test our new class of genetically engineered probiotics to eradicate multi-drug resistant Enterobacteriaceaespecies; Program 3: Develop another novel probiotic to sense Clostridium difficile expansion in the infected gut and to eradicate it through the production of C. difficile inhibitory compounds; and Program 4: Develop probiotic consortia to minimize the emergence of stress-induced physiological, neurological and behavioral negative outcomes including anxiety and PTSD.
Highlighted Publications:
- Intestinal Microbiota Containing Barnesiella Species Cures Vancomycin-Resistant Enterococcus faecium Colonization
- Precision microbiome restoration of bile acid-mediated resistance to Clostridium difficile
- Engineered Probiotic for the Inhibition of Salmonella via Tetrathionate-Induced Production of Microcin H47
- Microcin H47: A Class IIb Microcin with Potent Activity Against Multidrug Resistant Enterobacteriaceae